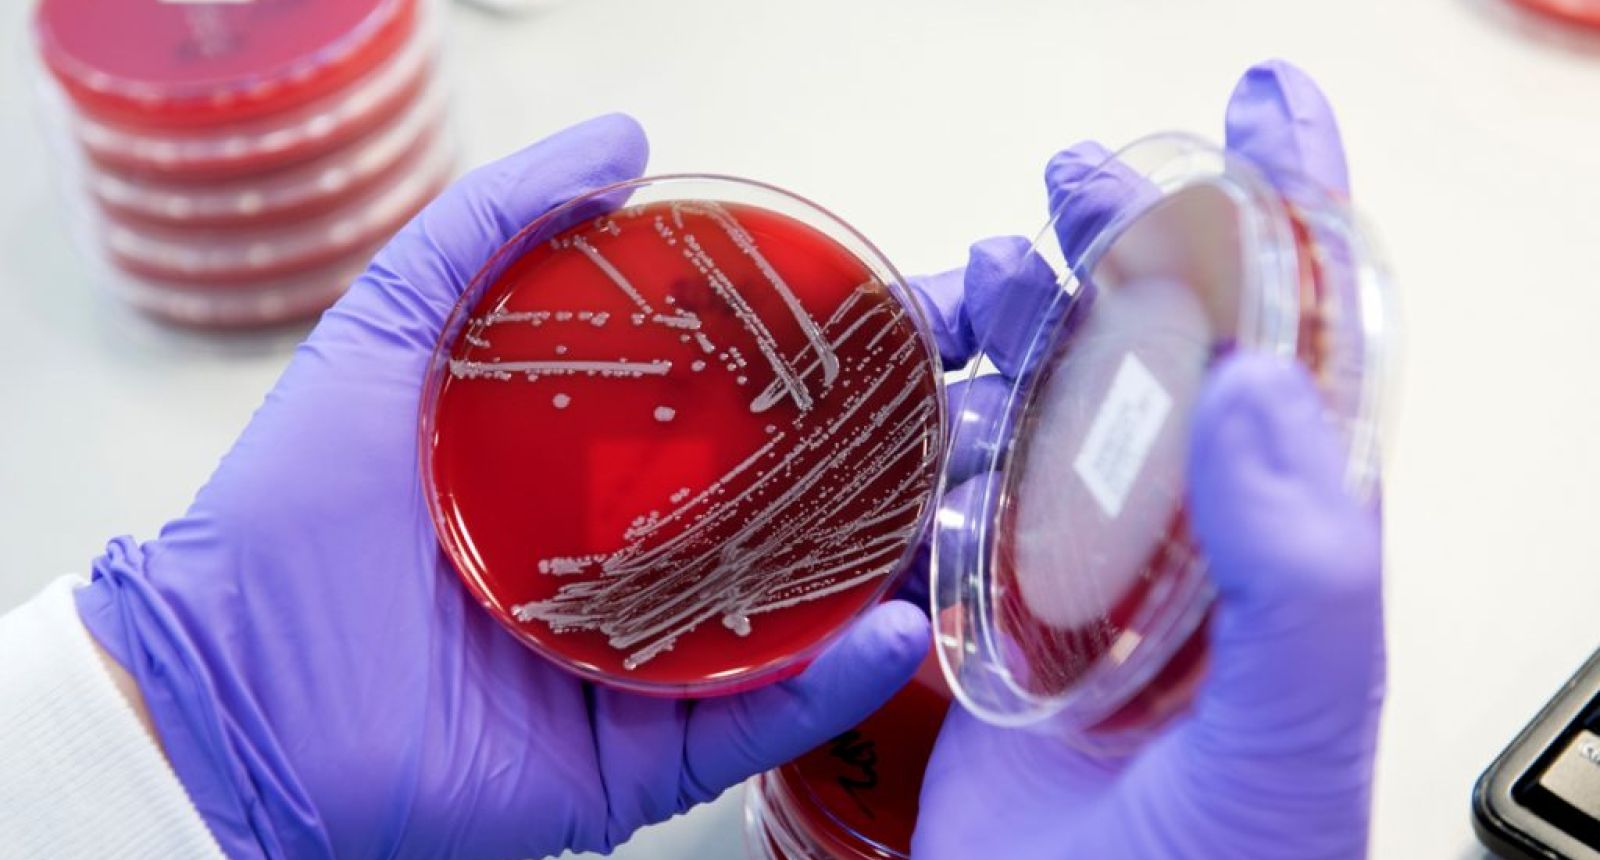
المخلفات الطبية المعدية (أطباق المزارع البكتيرية) 1 الإصابات الجرثومية لعمال نقل النفايات في المكبات العامة

الإصابات الجرثومية لعمال نقل النفايات في المكبات العامة
إصابة عمال نقل النفايات في المكبات العامة بالعدوى الجرثومية (البكتيرية) يُعتبر خطرًا صحيًا كبيرًا بسبب تعرضهم المباشر للنفايات الملوثة بأنواع مختلفة…
المخلفات الطبية الباثولوجية
هي أنسجة وبقايا أعضاء بشرية مثل المشيمة، ومخلفات العمليات الجراحية من أعضاء المستأصلة، أجنة بشرية، بقايا حيوانات استخد…
المخلفات الطبية المعدية
عشرون معمل للتحاليل الطبية بمدينة طرابلس ينتجون حوالي 7.4 طن نفايات طبية معدية على شكل أطباق المزارع البكتيرية، وبعد ا…
مخلفات الغازات المخدرة
مخلفات الغازات المخدرة (Waste Anesthetic Gases) هي كميات صغيرة من غازات التخدير المتطايرة التي تتسرب من دائرة التنفس…
Latest Business
معالجة أكياس وحدات الدم المرفوضة في مصارف الدم: التطهير بالكيماويات أو التعقيم بالبخار
من أكثر الأشياء التي تزعج العاملين في مصارف الدم هو التخلص من أكياس وحدات الدم المرفوضة (Rejected Blood Units Bags) بسبب إحتوائها على ميكروبات الدم الخطيرة بعد ظهور نتائج التحاليل الطبية عليها أو أكياس وحدات الدم التي أنتهت فترة صلاحيتها للأستعمال.
تنتج مصارف الدم المركزية في الدول ذات الك…
حفنة من الأوساخ
أعتقد أهالي قرية موزيفا في أقليم زمبيزيا بموزمبيق أنهم أكتشفوا كنز عندما أخدوا حفنة من التراب المتسخ وجدوه مرمي قرب قريتهم وألقوه في البحيرة، ففي لحظات طفت كمية من الأسماك الميته على السطح والتي كان سيستغرق منهم وقت كبير وأدوات غير متاحة لهم لصيد تلك الكمية، وبسرعة قاموا ببيع تلك الأسماك في السوق…
المخاطر الصحية المترافقة لمهنة نبش القمامة في الأطفال
الحقيقة التي يعرفها المهتمين بأدارة النفايات الصلبة أن الألف من الأطفال والمراهقين في دول العالم الثالث في أفريقيا وأسياء وأمريكا الجنوبية قد أمتهنوا مهنة نبش القمامة (The Occupation of Waste Picking) للعيش والأسترزاق منها لهم ولأسرهم بسبب العوز والفاقة وعدم وجود خيارات أخرى متاحة لهم.
فتج…
الإدارة السليمة للمخلفات الطبية
من أهم الركائز الأساسية لإدارة النفايات الطبية وأهم سبل إنجاحها هو القيام بعملية فرز النفايات الطبية عن غير طبية بطريقة جيدة وهذا يبتدي منذ لحظة إنتاج النفايات في الأقسام العلاجية.
هل يجوز في الشريعة الأسلامية حرق الأنسجة والأعضاء البشرية للتخلص منها؟
خلال نقاش مع زميل ذكر لي أن النفايات الطبية الباثولوجية المثمتلة في الأنسجة المنزوعة والأطراف المبثورة التي نزعت من الإنسان لأسباب طبية علاجية يجب إحترامها بدفنها وعدم حرقها في محارق بأي حال من الأحوال، فعند حرقنا لها فذلك تشبه لفعل بعض الملل والأديان الأخرى وهذا لا يجوز.
مثل هذا النقاش ت…
الكنديدا أوريس: جرثومة جديدة مقاومة للأدوية تنتشر في المستشفيات ومرافق الرعاية الصحية في العالم
أعلان المركز الأمريكي للتحكم في الأمراض (CDC) عن ظهور نوعًا جديد من الفطريات (الخمائر) تُدعى الكنديدا أوريس (Candida auris) في العديد من المنشآت الرعاية الصحية في أمريكا وفي عدد من بلدان العالم. تُسبب أمراض شديدًا في المرضى بالمستشفيات، بحيث يمكن لهذا الفطر أن يدخل مجرى الدم (Fungemia) وينتشر في…